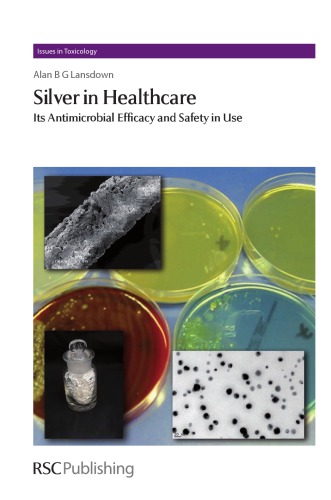
نقره در مراقبت های بهداشتی: اثربخشی ضدمیکروبی و ایمنی در استفاده ۲۰۱۰

سیمکولی نقرهای ۲۰۲۲
Silver Bream 2022
دانلود کتاب سیمکولی نقرهای ۲۰۲۲ (Silver Bream 2022) با لینک مستقیم و فرمت pdf (پی دی اف) و ترجمه فارسی
| نویسنده |
Mark Everard |
|---|
ناشر:
CRC Press

۳۰ هزار تومان تخفیف با کد «OFF30» برای اولین خرید
| سال انتشار |
2022 |
|---|---|
| زبان |
English |
| تعداد صفحهها |
80 |
| نوع فایل |
|
| حجم |
6.6 MB |
🏷️ 200,000 تومان قیمت اصلی: 200,000 تومان بود.129,000 تومانقیمت فعلی: 129,000 تومان.
🏷️
378,000 تومان
قیمت اصلی: ۳۷۸٬۰۰۰ تومان بود.
298,000 تومان
قیمت فعلی: ۲۹۸٬۰۰۰ تومان.
📥 دانلود نسخهی اصلی کتاب به زبان انگلیسی(PDF)
🧠 به همراه ترجمهی فارسی با هوش مصنوعی
🔗 مشاهده جزئیات
دانلود مستقیم PDF
ارسال فایل به ایمیل
پشتیبانی ۲۴ ساعته
توضیحات
معرفی کتاب سیمکولی نقرهای ۲۰۲۲
این کتاب تقدیم به سیمکولی، ماهیای که مدتهاست از سوی ماهیگیران، علاقهمندان به حیات وحش و دانش، نادیده گرفته شده است.
در واقع، این نخستین کتابی است که بهطور اختصاصی به این ماهی آب شیرین میپردازد.
دکتر مارک اورارد، دانشمند، نویسنده و مجری، در این کتاب به معرفی زیستشناسی سیمکولی، روشهای صید این ماهی و ویژگیها و ارزشهای اجتماعی گوناگون آن میپردازد.
فهرست کتاب:
۱. جلد
۲. صفحه عنوان فرعی
۳. عنوان
۴. حق تکثیر
۵. فهرست مطالب
۶. یک مقدمه
۷. دو سیمکولی نقرهای چیست؟
۸. سه صید سیمکولی نقرهای
۹. چهار سیمکولی نقرهای و مردم
۱۰. کتابشناسی سیمکولی نقرهای
توضیحات(انگلیسی)
This book is dedicated to the Silver Bream, a fish too long neglected by anglers, wildlife enthusiasts and science.
In fact, this is the first book ever devoted to this freshwater fish.
Scientist, author and broadcaster Dr Mark Everard introduces the biology of the silver bream, angling for this fish, and its diverse social quirks and values.
Table of Contents
1. Cover
2. Half Title
3. Title
4. Copyright
5. Contents
6. One Introduction
7. Two What Is a Silver Bream?
8. Three Silver Bream Fishing
9. Four Silver Bream and People
10. Silver Bream Bibliography
دیگران دریافت کردهاند
نانوذرات نقره ۲۰۲۳
Silver Nanoparticles 2023
🏷️ 200,000 تومان قیمت اصلی: 200,000 تومان بود.129,000 تومانقیمت فعلی: 129,000 تومان.
طلوع امید: مزایای بلایای طبیعی ۲۰۲۱
The Silver Lining: The Benefits of Natural Disasters 2021
🏷️ 200,000 تومان قیمت اصلی: 200,000 تومان بود.129,000 تومانقیمت فعلی: 129,000 تومان.
کاتالیز نقره در سنتز آلی ۲۰۱۸
Silver Catalysis in Organic Synthesis 2018
🏷️ 200,000 تومان قیمت اصلی: 200,000 تومان بود.129,000 تومانقیمت فعلی: 129,000 تومان.
نقره ۲۰۱۷
Silver 2017
🏷️ 200,000 تومان قیمت اصلی: 200,000 تومان بود.129,000 تومانقیمت فعلی: 129,000 تومان.
نقره در مراقبت های بهداشتی: اثربخشی ضدمیکروبی و ایمنی در استفاده ۲۰۱۰
Silver in Healthcare: Its Antimicrobial Efficacy and Safety in Use 2010
🏷️ 200,000 تومان قیمت اصلی: 200,000 تومان بود.129,000 تومانقیمت فعلی: 129,000 تومان.
نقره در مراقبت های بهداشتی: اثربخشی ضدمیکروبی و ایمنی آن در استفاده ۲۰۱۰
Silver in Healthcare: Its Antimicrobial Efficacy and Safety in Use 2010
🏷️ 200,000 تومان قیمت اصلی: 200,000 تومان بود.129,000 تومانقیمت فعلی: 129,000 تومان.
✨ ضمانت تجربه خوب مطالعه
بازگشت کامل وجه
در صورت مشکل، مبلغ پرداختی بازگردانده می شود.
دانلود پرسرعت
دانلود فایل کتاب با سرعت بالا
ارسال فایل به ایمیل
دانلود مستقیم به همراه ارسال فایل به ایمیل.
پشتیبانی ۲۴ ساعته
با چت آنلاین و پیامرسان ها پاسخگو هستیم.
ضمانت کیفیت کتاب
کتاب ها را از منابع معتیر انتخاب می کنیم.